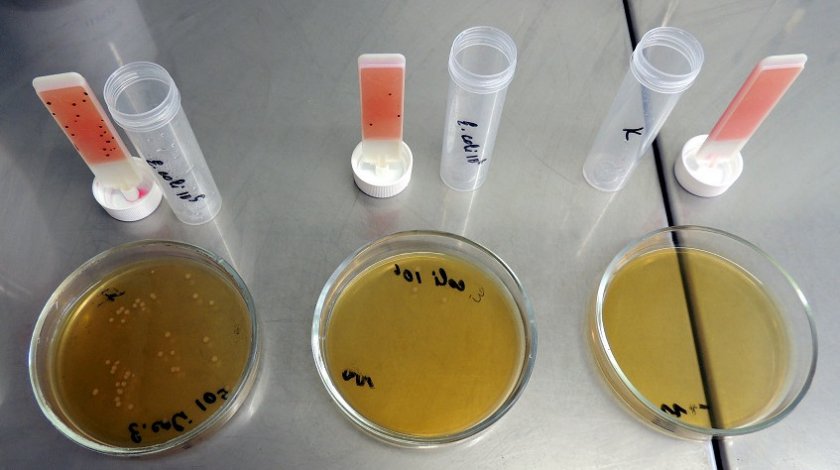

Сколько рамок с медом оставить пчелам на зиму в улье: всего можно и нужно
Содержание
- 1 Сколько рамок с медом оставить пчелам на зиму в улье: всего можно и нужно
- 1.1 Благополучная зимовка пчел
- 1.2 Сколько килограммов мёда надо для зимовки пчёл
- 1.3 Зачем пчёлам мёд на зиму
- 1.4 Какое количество мёда оставить
- 1.5 Сборка пчелиных ульев на зиму
- 1.6 Как утеплить пчелиное гнездо
- 1.7 Изготовление рамок для ульев своими руками
- 1.8 Как установить разделительную решётку для пчелиных ульев на зиму
- 1.9 Правила и методы отбора качественного мёда для зимовки пчёл
- 1.10 Сколько рамок с медом оставлять пчелам на зиму
- 1.11 Зачем пчелам мед и сколько
- 1.12 Какое количество меда необходимо оставить для комфортной зимовки пчел?
- 1.13 Какой мед запасать на зиму
- 1.14 На скольких рамках зимуют пчелы
Благополучная зимовка пчел
Собирая гнезда пчел на зиму, необходимо определить количество пчел в каждой семье (силу семьи), чтобы установить число рамок, которое надо оставить семье в зиму и, исходя из этого, определить количество меда, которое ей необходимо. В зиму оставляют лишь те рамки, которые содержат не менее 1,5 кг меда, а лучше 2—2,5 кг меда. Рамки с меньшим количеством меда следует удалять и заменять более полновесными. При соблюдении этого требования пчелам всегда хватит корма на тех рамках, на которых разместился клуб с осени. Пчелы будут иметь в таком случае по 8—10 кг меда непосредственно на освоенных клубом сотах и этим медом будут питаться в наиболее холодный период зимы. Зимуя на сотах, хорошо заполненных медом, клуб пчел никуда не будет перемещаться с рамок, занятых с осени, а это и есть важнейшее требование успешной зимовки.
Важное значение при формировании клуба имеет расположение летка. Пчелы размещают с осени расплод у летка, и тут же у них образуется центр клуба. Лучшие результаты зимовки получаются, когда клуб размещается не в середине, а с края гнезда, ближе к южной стенке улья. Тогда пчелы будут иметь запасы меда, размещенные лишь к одной стороне. Если почему-либо пчелы израсходуют весь мед па тех рамках, где клуб сел с осени, то клуб зимой сможет переместиться лишь в одном направлении (к северной стенке улья), где сосредоточены все остальные запасы; раздвоения клуба и гибели семей при этом не произойдет.
Чтобы клуб разместился не в середине, а сбоку гнезда, пользуются таким приемом: после окончания главного взятка сразу же при сокращении гнезд и летков в ульях оставляют уменьшенный леток не у середины гнезда, а сбоку, ближе к южной стенке. Соответственно этому расплод, а затем и клуб, будут формироваться с осени с края гнезда.
Ульи с полурамочными магазинами часто затрудняют сборку гнезд на зиму, так как лучший мед в этих ульях складывается в полурамках, а в гнездах может не оказаться достаточного количества полновесных рамок. В таких случаях можно оставлять пчел на зиму с медовыми магазинами. Однако для слабых и средних семей необходимо подобрать полновесные гнездовые рамки.
Предварительно собирая гнезда на зиму, пчеловод должен дать каждой семье нужное количество медовых сотов, отобрав излишки или добавив меда, если его недостаточно. При желании пополнить медом рамки, оставленные в гнезде, ставят маломёдные рамки, намеченные к отбору, за вставной доской и распечатывают в них мед; пчелы постепенно перенесут его в гнездо и сложат в оставленных там рамках.
В тех случаях, когда почему-либо нет в достаточном количестве полновесных медовых рамок и приходится использовать для зимовки и маломёдные рамки (по не меньше 1 кг), размещать их в гнезде лучше всего следующим образом: к южной стенке улья ставится наиболее полновесная медовая рамка; за ней 1—2 рамки с расплодом (если еще весь расплод не вышел). Эти рамки должны приходиться против летка. Если в них очень мало меда, то после выхода расплода их удаляют. Затем ставят снова наиболее тяжеловесные медовые рамки, а дальше к краю гнезда — рамки с постепенно уменьшающимся количеством меда. В таком случае клуб соберется с южной стороны гнезда и будет иметь в своем распоряжении тяжеловесные медовые рамки, в которых меда должно хватить пчелам на холодный период.
Сколько килограммов мёда надо для зимовки пчёл

Чтобы семья пчёл сохранилась на следующий год, следует тщательно подготовить её к зиме. Ульи должны быть качественно сделаны и утеплены, но обязательным условием для пчёл является необходимый корм — запас мёда, который пчеловод обязан оставить насекомым. Подробнее о том, сколько пищи нужно пчёлам для зимовки, а также как к ней подготовиться — далее в статье.
Зачем пчёлам мёд на зиму
Мёд — это основное питание пчёл, и без него пчелиная семья просто не сможет пережить зиму. Насекомые производят его из нектара и пыльцы цветов, а также добавляют специальные ферменты, которые не дают ему испортиться. Поскольку в нектаре содержится большой процент влаги, её нужно удалять, и для этого в ульях должна быть вентиляция для проветривания. 
Пчеловоды забирают часть мёда, и во время зимовки необходимо подкармливать пчёл сахарным сиропом — он помогает насекомым не потерять силы и не даёт пчелиной семье погибнуть от голода.
Какое количество мёда оставить
Важно правильно рассчитать количество мёда для пчёл, чтобы сохранить всех особей следующему тёплому сезону. Помимо питания важно также определиться с местом, в котором пчёлы будут зимовать, — в тепле расход мёда будет минимальным, тогда как в холоде возрастёт приблизительно на 40%.
Пребывание зимой ульев в тёплом помещении
Для зимовки в помещении пчёлам будет достаточно около 8 килограммов мёда на 1 семью. Меньше оставлять нежелательно — недостаток питания приводит к тому, что яйцекладка весной уменьшается из-за недостатка еды в улье. 
Кроме того, как уже упоминалось, обязательным пунктом должна быть подкормка пчёл сахарным сиропом. Его можно приготовить, смешав сахар, воду и уксус.
Зимовка на улице
Если нет возможности занести ульи на зимовку в помещение, то пчеловоды оставляют ульи на улице, предварительно утеплив их. В таком случае количество корма для пчёл должно быть большим — около 11 кг из расчёта на 1 семью.
Сборка пчелиных ульев на зиму
Ульи на зимовку начинают собирать с начала осени, сроки сбора должен быть не позже середины сентября.
Существуют 2 вида сборки ульев:
- Односторонняя. С одной стороны размещают соты в таком порядке: 1 рамка на 3,5 кг, далее — на 1,5 кг, 3 рамки на 2 кг, 1 — на 2,5 кг. Последними идут 2 рамки на 3 кг.
- Двусторонняя. В середине улья оставляют 2 рамки до 2 кг мёда, после с каждой стороны ещё по 1 рамке на 2 кг, за ними — на 3 кг.

Как правильно размещать кормовые рамки
Кормовые рамки необходимо размещают исходя из семьи пчёл. Если пчёлы сильные и выносливые, то рамки должна вмещать в себя до 9 кг мёда. Для средних по силе пчёл стоит выделить 6 кг. А для нуклеусов будет достаточно 4 кг мёда. 
Обязательным условием подготовки питания для зимовки есть то, что все соты обязательно должны быть заполнены. Незаполненные соты медовых рамок начнут приводить в беспокойство пчёл, и они не будут спокойно зимовать. Это может привести даже к гибели многих особей.
Как утеплить пчелиное гнездо
Утепление улья зависит от видов зимовки:
- в омшаниках, когда ульи убирают под землю в специальное помещение;
- на улице, когда оставляют на том же месте.
При внутреннем утеплении важно помнить, что не следует утеплять улей и особенно потолок полиэтиленом — он не будет пропускать влагу, соответственно это приведёт к повышению влажности и появлению грибка. Лучше накрывать крышу улья хвоей. Для внутреннего утепления также отлично подойдут хвоя, мох, ореховые листья. Если используется искусственный утеплитель, он должен хорошо пропускать воздух. 
Для тех ульев, которые остаются зимовать на улице, используют специальные щиты для утепления. Пространство между стенками ульев и щитами необходимо заполнить сухими листьями ореха или хвоей.
Изготовление рамок для ульев своими руками
Рамки для медовых сот можно не только купить в специальном магазине, но и сделать самостоятельно.
Для сооружения рамок подойдет древесина таких пород:
- липа;
- тополь;
- кедр;
- ива;
- осина.
Чтобы изготовить рамки, понадобится станок, в его качестве подойдёт металлический стол со встроенной в него циркулярной пилой.
- бруски;
- накладной столик;
- толкатель, который выполнен из дерева;
- направляющий уголок;
- доски для боковых сторон.

Пошаговая инструкция к изготовлению рамок своими руками:
- Прежде всего просушить древесину, из которой вы будете изготавливать рамки. Допустимое количество влаги составляет не более 15%.
- Каждую заготовку после качественного просушивания проверить на трещины и сучки. Все детали обязательно должны быть гладкими, без всяких зацепок. Если их нет, то можно смело приступать к обработке материала. В основном популярен метод изготовления по Дадану. Размер рамки по Дадану обычно составляет 43,5 см в длину и 30 см в высоту. В корпусе такого улья свободно помещаются 12 рамок для пчёл. Дополнением есть то, что в улей вставляется ещё и магазин, его длина составляет также 43,5 см, а высота — вдвое меньше, 14,5 см.
- Нарезать бруски с помощью накладного столика, который используется при создании рамок. Этот столик служит тем, что помогает нарезать бруски и одинаковых размеров, а также позволяет обезопасить работу с пилой.
- После выпиливания также желательно просушить заготовки. Сушка занимает 3 дня.
- После сушки провести соединение боковых рамок и всех планок между собой.
Видео: Пчеловодческие рамки для ульев своими руками
Как установить разделительную решётку для пчелиных ульев на зиму
Разделительные решётки в пчелином гнезде устанавливают для того, чтобы повысить сбор мёда, а также выведение новых, сильных пчёл. За счёт разделения соты с пчелиным расплодом будут отделены от рамок с мёдом. Кроме того, такие сетки помогают сохранять ульи от нашествия мышей и других вредителей. 
Решётку устанавливают так, чтобы прорези сетки были параллельны верхним брускам рамки. Расстояние между ними не должно превышать 8 мм, а между нижними — не более 5 мм. Периодически стоит поднимать решётку, так как на ней может сидеть много трутней, которых следует выпускать.
Правила и методы отбора качественного мёда для зимовки пчёл
Для отбора качественного мёда следует провести ряд анализов, которые покажут наличие в мёде пади. Это сладкая жидкость, которую выделяют насекомые, которые питаются соком растений. В отличие от нектара, падевый мёд не содержит фитонцидов и других полезных веществ. У пчёл, питающихся падью, продолжительность жизни может снижаться более чем вдвое. 
Уксусно-свинцовый способ
Для проведения анализа данным способом используется специальная походная лаборатория Темнова.
Предметы, которые понадобятся для лаборатории:
- чемодан для пробирок;
- стеклянная чаша;
- компаратор;
- флакон с водой;
- кристаллический уксуснокислый свинец;
- дистиллированная вода;
- большая пипетка для воды;
- маленькая пипетка для реактивов.
Пошаговая инструкция метода:
- В небольшую пробирку набрать мёд, приблизительно 1/5 часть, и залить водой.
- Перелить всё содержимое в большую пробирку.
- В маленькую пробирку вновь налить воды, стараясь смыть остатки мёда с неё. Перелить всё в большую.
- В раствор добавить 2 капли уксуснокислого свинца.
- Тщательно перемешать.
- Поставить пробирку в компаратор и сквозь него посмотреть, как через очки, на линию горизонта.
- Рядом стоит контрольная пробирка с цветочным мёдом. Если через первую пробирку не видно линии горизонта, то пади слишком много.
- Чтобы лучше определить проверяемый пчелиный мёд на количество пади, в него по капле добавлять воду до того момента, пока прозрачность не сравняется с контрольной пробиркой.
- Если при добавлении воды количество капель — больше 60, то мёд некачественный и его лучше не использовать для подкормки.

Спиртовой анализ
Смешать мёд и дистиллированную воду в соотношении 1:1. Далее нужно взять 10 частей винного спирта и всё тщательно перемешать между собой. Если начинают появляться мутные вкрапления, то в мёде содержится падь.
Известковый анализ
Смешать 1 часть мёда и 1 часть дождевой воды, если её нет, то можно использовать дистиллированную. Также к смеси добавить 2 части известковой воды, которую можно приготовить самостоятельно — для этого надо 100 г негашеной извести залить 1 л холодной воды, тщательно перемешать и процедить через марлю.
Далее подготовленную смесь нагреть до кипения и рассмотреть: если есть хлопья, которые выпали в осадок, — это говорит о том, что в продукте присутствует падь.
Для подготовки пчёл к зимовке необходимо не только заготовить нужное количество мёда для питания насекомых, но и проверить его качество. А регулярный уход за ульями поможет пчелиным семьям без проблем пережить зиму и в следующем сезоне приступить к своей привычной работе.
Сколько рамок с медом оставлять пчелам на зиму
Работа пчеловодов на пасеке с приходом осени не заканчивается: они готовят рабочую пасеку к зимнему периоду, им нужно сформировать пчелиные гнезда. Чтобы пережить длительную зиму, пчелиная семья требует определенное количество корма. Именно по этой причине все пасечники должны знать, сколько меда оставлять пчелам на суровую зиму.
Зачем пчелам мед и сколько
Многие насекомые и букашки впадают в зимнюю спячку на время холодов, но пчелы активны даже зимой. По этой причине у пчел отсутствует привычка к накоплению питательных веществ для зимовки. Поэтому пчеловоду необходимо снабдить своих питомцев живительным кормом на это время.
При дефиците корма пчелиные семьи развиваются слабее, это может вылиться в снижение показателей продуктивности в сезон.

Сколько рамок с медом оставлять пчелам на зиму
Какое количество меда необходимо оставить для комфортной зимовки пчел?
Всех начинающих пчеловодов интересует вопрос, сколько рамок с медом оставлять пчелам на зиму. Объем меда, который накапливают к зиме, зависит от выбранного способа зимовки пчел.
Имеются 2 пути зимовки пчел:
- Пребывание в теплом помещении, если зимующая пасека расположена в помещении, где уровень воздушной температуры держится на уровне +2 градусов. При таком раскладе потребление живительного меда будет сведено к минимуму – до 8 кг на одну развитую пчелиную семью;
- Зимовка на вольных просторах. Если пчелиные ульи находятся на улице, то при средней температуре -20 градусов одна пчелиная семья может съесть до 13 кг полезного продукта.
Все припасы необходимо разместить на рамах, одна способна вместить до 2,5 кг меда. Сколько рамок оставлять в улье на зиму? Это зависит от способа зимовки, в помещении понадобится около 3 рам, на улице – до 5 рамок.

На улице нужно оставлять до пяти рамок
Какой мед запасать на зиму
Чтобы быть спокойным за зимовку пчелиной семьи, пасечнику необходимо накопить качественный продукт. Выбранный сорт значения не имеет, только вересковый и паевый виды меда накапливать на зиму все же не стоит.
Паевый мед рабочие пчелы вырабатывают, когда не удается получить достаточное количество живительного нектара. В этот период насекомые вместо нектара используют соки, выделяемые взрослыми деревьями. Человеку можно потреблять этот вид медового продукта, поскольку он отличается безопасностью для хрупкого здоровья. Но если трудовые пчелы будут в больших количествах потреблять паевый продукт, то есть риск гибели ценных насекомых.
Особенно пагубными для здоровья пчел-тружениц являются остатки белкового обмена, которые в избытке содержатся в этом продукте. Эти компоненты являются остатками жизнедеятельности тли, других пагубных вредителей. Произвести очитку паевого продукта от губительных примесей практически невозможно. Пчеловоды определяют наличие в составе продукта паевых примесей с помощью специальных реагентов:
- Уксусно-свинцовый способ определения наиболее верный. Он определяет паевые примеси с точностью в 100%;
- Простой спиртовой анализ, но точности в этом методе мало. Зачастую положительные результаты в спиртовом анализе получаются и у гречишного меда;
- Известковый анализ применяют на постоянной основе. С этой целью незначительное количество негашеной извести заливают очищенной водой. С полученного раствора сливают отстоявшуюся жидкость. Она и является реагентом для выявления паевых примесей в пчелином продукте.

Вересковый медовый продукт никакой опасности для жизнедеятельности пчел не представляет, но с течением временем он сильно густеет, поэтому насекомым становится сложнее потреблять его в пищу. Комфорт зимовок зависит не только от количества накопленного меда в улье, но и от качества выбранного продукта. Пчеловоды решают оставить светлый медовый продукт для зимнего периода проживания пчелиной семьи, поскольку в темных сортах содержание трудноперевариваемых компонентов намного больше. Такие виды плохо усваиваются трудовыми пчелами.
На скольких рамках зимуют пчелы
Любого начинающего пасечника интересует вопрос, на скольки медовых рамках должны зимовать пчелы, чтобы зимовка прошла для них комфортно и без потерь. После оставления необходимого количества живительного продукта пчеловод заботится о том, чтобы правильно распределить корм по рамам.
В качестве сырья для заготовок выбирают соты светло-коричневого оттенка, именно в этой среде появилось наибольшее количество пчел. Рамы с сотами темного тона не годятся для зимних заготовок, в них имеются остатки зародышевых пчел, которые остаются от прошлогоднего производства.
Внимание! Рамочные ячейки должны быть плотно запечатаны, в незапечатанных ячейках пчелиный мед закисает, становится жидким. При размещении улья в проветриваемом помещении есть риск того, что мед начнет кристаллизоваться.
В зависимости от конструкции улья, в рамочных устройствах установка корма происходит быстро и легко. Отбор медового продукта из многокорпусного улья из первого корпуса осуществляют в полной мере, со второго – лишь наполовину. Оставшиеся незаполненными рамы перемещают на середину. Если в улье уже имеется 12 рам, то необходимо организовывать систему для хранения зимних припасов. С этой целью мастерят дополнительный корпус с двумя пустыми магазинами, где будут располагаться медовые рамы. После полного заполнения медом их отправляют до осени на хранение.
Бывают моменты, когда корм для рабочих пчел заготовить не удается, в таком случае пасечники применяют различные подкормки. Вводить прикорм начинают после окончания взятка, в этом случае введение подпитки может негативно сказаться на здоровье пчел, что приведет к снижению сезонной продуктивности.
В качестве сырья для подкормки подойдет сахарный сироп, консистенция у него средняя: не слишком густой и не слишком жидкий. Давать приготовленный сироп необходимо в ночное время суток, перед этим состав подогревают. Вводят питательный состав дозированно, по 1 стакану в неделю. Насекомые потребляют до 25% введенного сахара, при скармливании 1,5 кг готового сиропа улей произведет 1 кг чистого меда.Все эти простые действия помогут пчелиному сообществу легко и с комфортом пережить суровую зиму.
Источники:
http://www.meedov.ru/beewinter/prosheritywinterer/13.html
http://fermer.blog/bok/pchelovodstvo/pchely/soderzhanie-pchel/zimovka-pchel/8833-skolko-ramok-ostavljat-v-ule-na-zimu.html
http://7ogorod.ru/prochee/skolko-ramok-ostavlat-pcelam.html
